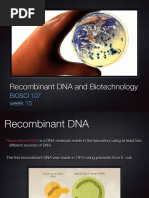

0% found this document useful (0 votes)
14 views29 pagesDNA Sequencing
The document outlines various methods and applications of DNA sequencing and analysis, including automated DNA sequencing, the Maxam-Gilbert method, and DNA fingerprinting. It discusses the Human Genome Project, tissue and animal cell culture techniques, and the development of transgenic organisms, highlighting their benefits and ecological concerns. Additionally, it covers the use of biotechnology in human health, including disease diagnosis and gene therapy for conditions like cystic fibrosis.
Uploaded by
Farhad khanCopyright
© © All Rights Reserved
We take content rights seriously. If you suspect this is your content, claim it here.
Available Formats
Download as PPTX, PDF, TXT or read online on Scribd
0% found this document useful (0 votes)
14 views29 pagesDNA Sequencing
The document outlines various methods and applications of DNA sequencing and analysis, including automated DNA sequencing, the Maxam-Gilbert method, and DNA fingerprinting. It discusses the Human Genome Project, tissue and animal cell culture techniques, and the development of transgenic organisms, highlighting their benefits and ecological concerns. Additionally, it covers the use of biotechnology in human health, including disease diagnosis and gene therapy for conditions like cystic fibrosis.
Uploaded by
Farhad khanCopyright
© © All Rights Reserved
We take content rights seriously. If you suspect this is your content, claim it here.
Available Formats
Download as PPTX, PDF, TXT or read online on Scribd